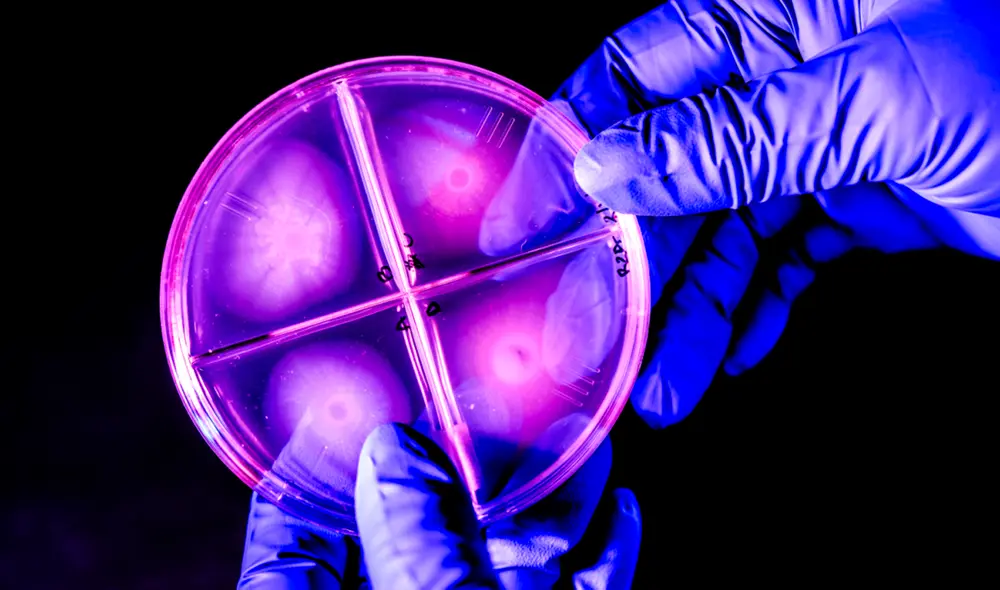
Verónica Godoy-Carter, profesora adjunta de biología, descubrió una bacteria violeta entre antiguas “rocas vivas” de la Patagonia. Foto: Matthew Modoono/Northeastern University

Científicos descubren en Sudamérica unos organismos vivos que existen casi desde que comenzó la vida en la Tierra
Investigadores hallaron en la Patagonia chilena microorganismos antiguos con miles de millones de años de existencia que viven en condiciones extremas.
- ¿Por qué más del 60% de los meteoritos encontrados en la Tierra provienen de las áreas de hielo azul de la Antártida?
- Descubren una nueva especie de anaconda gigante y mide más de 5 metros de largo: los machos y las hembras son increíblemente diferentes
Un equipo de biólogos de la Universidad de Northeastern identificaron colonias de bacterias extremófilas en formaciones rocosas conocidas como estromatolitos que han sobrevivido desde tiempos remotos en la Patagonia chilena. Se trata de microorganismos resistentes que podrían haber existido casi desde el origen de la vida en la Tierra.
El estudio, liderado por la bióloga Verónica Godoy-Carter, publicado en Microbiology Resource Announcements, secuenció el genoma bacteriano de estos organismos, descubriendo que poseen un pigmento violeta que los protege de la radiación ultravioleta. Su análisis sugiere que estos biofilms resistentes, formados por comunidades bacterianas, fueron clave en la evolución de la vida primitiva.
La vida microbiana que habita en "rocas vivientes"
La investigación comenzó en 2018 con una expedición a la Patagonia chilena. Durante la exploración, el equipo identificó microorganismos del género Janthinobacterium, conocidos por su capacidad para sobrevivir en ambientes extremos. “Se cree que este tipo de formaciones creadas por bacterias son, en gran medida, las primeras células vivas, células organizadas, de la Tierra”, explicó Godoy-Carter.

Primer plano de una bacteria encontrada en el laboratorio de Godoy-Carter. Foto: Matthew Modoono/Northeastern University.
Estas bacterias, que habitan en las llamadas "rocas vivientes", tienen estructuras multicelulares robustas y son capaces de resistir temperaturas extremadamente bajas. Los científicos creen que su pigmento morado bacteriano no solo es responsable de su color característico, sino que también actúa como un escudo contra la radiación solar.
"Con los biofilms podemos fabricar nuevos plásticos, nuevos textiles, tal vez podríamos crear textiles con el pigmento, y quizás el pigmento proteja de la luz UV", explica Godoy-Carter sobre las posibilidades futuras.
El desafío de trabajar con bacterias fuera de su entorno salvaje
A pesar del avance en la secuenciación del genoma, estudiar estos organismos representa un reto. "No se adaptan fácilmente al laboratorio, tienden a cambiar su comportamiento y dejan de producir ciertas sustancias", explicó Godoy-Carter. Para abordar este problema, los investigadores trabajan en la transferencia de sus genes a bacterias más manejables, denominadas "chasis", con el objetivo de facilitar su estudio y aplicación en distintos campos.

La bacteria Janthinobacterium forma biopelículas que pueden restringir el contenido de los tubos de ensayo.
El descubrimiento de estas bacterias ancestrales en la Patagonia chilena no solo amplía el conocimiento sobre la evolución de la vida en la Tierra, sino que también abre la puerta a nuevos desarrollos en biotecnología y biología molecular.
¡Sigue a La República en WhatsApp! Únete a nuestro canal desde tu celular y recibe las noticias más importantes de Perú y el mundo en tiempo real.



















